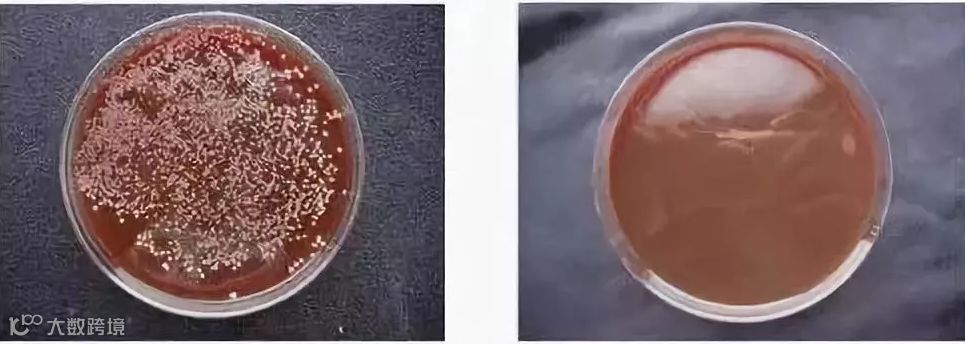

国人爱吃,对入口的食物忒讲究,但对口腔健康,却常常不是很上心。
我也是,平日里去超市买牙膏都看眼缘,没啥特别的品牌喜好,瞅到哪个用哪个。或者看到促销,囤它个十几支,实在不走心。

直到朋友聚会,嘴里喷出都是一阵酸臭味,让人没啥兴致唠嗑,互相躲都来不及,尴尬。
终于意识到不对劲,去看了牙医,被狠狠“数落一顿”,然后带(宰)我做了4000块的口腔护理…真心说,确实有效果。

但实在是太!贵!了!
我找了半天终于找到,从除口臭到除菌、美白齐活儿——来自韩国的麦斯特凯斯乳香牙膏,今天强烈推荐给你!
别看小小一支,效果一点不比所谓的牙齿护理差。

好久之前就已经火的不行了,我身边使用过的同事给它留下的评价是这样的:
·市面上牙膏跟它比都输了
·废啥话,这是我用过最好闻的牙膏
·简直近乎完美啊~我爹多年的口臭减轻了不少
·给!我!选!它!(嘶吼)
△识别上方图片即可购买△
售价:99元
限时活动价:89元
限时优惠截止时间:5月31日23:59
一个成熟的牙膏,最抓人的当然是:除口臭效果到底咋样,毕竟闭着嘴巴呼气都臭真的恼人。
在口臭、牙周炎的重要致病菌—牙龈卟啉培养液里投放1%乳香后,3分钟内明显被抑制。
乳香是此牙膏成分 左图中白点就是牙龈卟啉
口腔很是敏感的我爸,对牙膏也很挑剔,用完却赞不绝口:“里面没有任何刺激感觉,对口腔太友好了,还有股淡淡的松柏味儿,很舒服。”
使用一周,舌苔明显轻好多,早上起来口臭也没那么重了,用舌头转一圈,感觉口腔里的每一个角落都好干净!

这么好使的牙膏,我专门去查了查。
原来它刚出世,就拿奖拿到手软,2008年首尔国际发明展会:34个国家486个展品中摘得银奖,还获得了韩国专利厅的认证(发明名称:含乳香的牙膏组成物)。

左:获奖证明 右:专利证书(登记号码10-0795434)
几乎是每个韩国家庭必备的牙膏,在中国的各大购物网站也好评如潮。

都知道口腔有成百上千种细菌,除了引起口臭、牙周炎,甚至胃病都找上门。其中可怕的是幽门螺杆菌,藏在胃黏膜,连胃酸都杀不掉。
更恐怖的是非常好传染,尤其是小孩,一旦染上,很长时间要受它带来的侵扰。

轻一点是喉咙灼烧,上腹部隐隐作痛。一旦发展胃病,就会感觉胃被几万根针在扎,痛不欲生。

而这款牙膏如此受欢迎,除了除口臭效果好,还能解决以上口腔中的细菌问题。
也是市面上一款专针对幽门螺杆菌的牙膏。

效果如此强大正是因为含有“2%的乳香成分”。
说起杀菌,乳香效果据说是蜂胶的15.6倍,是众多口腔细菌的克星,而且比黄金还珍贵!
1支乳香牙膏所含乳香=2棵乳香树一年的产出

很多研究院都做了多项实验,乳香对抗幽门螺杆菌的作用,获得国内外的广泛认可。
新英格兰时报1998年12月24日和日本静冈县立大学,都证实了乳香对幽门螺杆菌的抑制作用。
↑向右滑动图片
它选用的天然乳香,是希腊(CHIOS)出产,已获得欧盟PDO原产地认证。
获得认证的重要原因:它是全球首款添加乳香的牙膏!全世界独此一家,别无分号!

↑认证报告
韩国生物科学与技术研究院又做了一个实验:把0.01g乳香添加到幽门螺杆菌的培养液中,3分钟内竟然可以达到99.99%的抑制率,太强悍!

使用时,高杀菌力的乳香会快速清理掉口腔里的细菌,并形成一道强力“防菌墙”
早晚只需要3分钟刷个牙的功夫,提前将细菌杀死在口腔中,替你省下不少医药费!


△识别上方图片即可购买△
售价:99元
限时活动价:89元
限时优惠截止时间:5月31日23:59
它还加入了羟基磷灰石(HAP)。
清除牙渍的同时,在表面自然形成保护层,把各种食用色素挡在牙齿外,让你再也不用担心抽烟、喝茶、咖啡让牙齿变黄了!
经常哭喊牙齿发黄不敢张嘴的同事反馈,坚持刷,一些顽固的牙菌斑少了很多,还越刷越白!

还可以很好的缓解改善牙龈出血,增强牙齿抵抗力,爱吃火锅夜宵烧烤的人选择它就对了。
这款牙膏的膏体沾水,泡沫丰富细腻,能清洁牙齿缝儿的每一个角落,轻松带走一天的食物残渣,大赞。

刷的时候有种松柏味,但是没国产牙膏的草药薄荷味那么浓,不会让人反感。
刷完嘴巴非常舒服,连抽烟的同事都说:口腔没有熏人的烟味,再也不用天天嚼口香糖了!

这款乳香牙膏让人放心的就是温和安全、不含氟、不含人工甜味剂,大人小孩放心使用。

每一支牙膏的含量是120g,每次挤出黄豆粒大小,足够你用两个月左右的了~
俗话说得好,花小钱,防大病,刷一次才几毛钱,无论是自用还是买给家人,都是不错的选择哦!快戳下面图片,在家里囤两只吧!
△识别上方图片即可购买△
售价:99元
限时活动价:89元
限时优惠截止时间:5月31日23:59
长按识别二维码 | 联系客服▼

(CIS)









